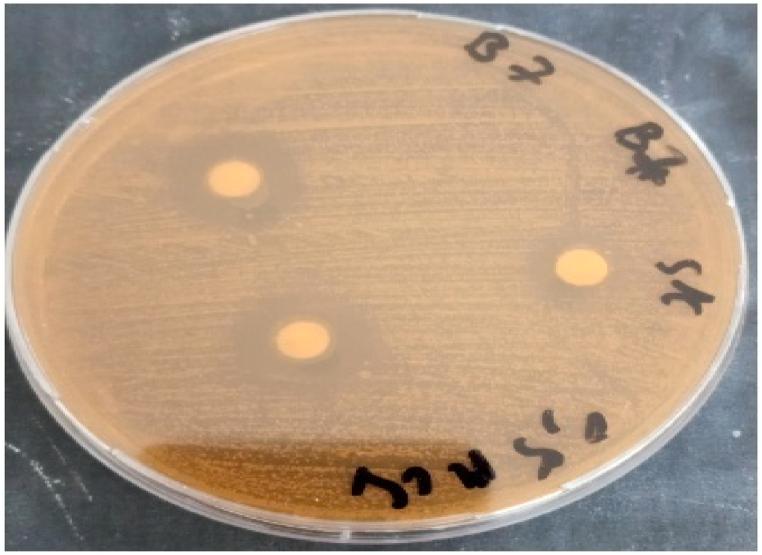
https://cdn.ncbi.nlm.nih.gov/pmc/blobs/fec1/11168319/c9e4abddde62/gr4.jpg

研究乳酸菌属特性:抗氧化活性、抗生素抗性以及对多重耐药菌的抗菌活性。
Investigating lactic acid bacteria genus properties: Antioxidant activity, antibiotic resistance, and antibacterial activity against multidrug-resistant bacteria .
作者信息
Hamdaoui Nora, Benkirane Chaymae, Bouaamali Haytham, Azghar Ali, Mouncif Mohamed, Maleb Adil, Hammouti Belkheir, Al-Anazi Khalid Mashay, Kumar Pankaj, Yadav Krishna Kumar, Choi Jeong Ryeol, Meziane Mustapha
机构信息
Laboratory of Agricultural Production Improvement, Biotechnology, and Environment, Department of Biology, Faculty of Sciences, University Mohammed Premier, 60000, Oujda, Morocco.
Laboratory of Environment and Applied Chemistry (LCAE), Faculty of Sciences, University Mohammed Premier, Oujda, Morocco.
出版信息
Heliyon. 2024 May 28;10(11):e31957. doi: 10.1016/j.heliyon.2024.e31957. eCollection 2024 Jun 15.
BACKGROUND
Lactic acid bacteria (LAB) are utilized as a starter culture in the manufacturing of fermented dairy items, as a preservative for various food products, and as a probiotic. In our country, some research has been carried out, even if LAB plays a principal role in food preservation and improves the texture and taste of fermented foods, that is why we tried to evaluate their probiotic effect. The objective of this research was to determine the antibacterial activity of ) against () ATCC 29213, investigate their antioxidant activity, and characterize their sensitivity against 18 antibiotics.
METHODS
A total of 23 LAB ( subsp. subsp. subsp. ) were isolated from cow's raw milk. The antibacterial activity was performed using two techniques, competition for nutrients and a technique utilizing components nature, using the disk diffusion method. The sensitivity of the studied LAB to different antibiotics was tested on Man rogosa sharp (MRS) agar using commercial antibiotic disks. All strains of LAB were examined for their antioxidant activity. The antioxidant activity of was tested by 2,2-diphenyl-1 picrylhydrazyl (DPPH).
RESULTS
The results showed that the MRS medium was more adapted than Muller Hinton Agar (MHA) to investigate the antibacterial activity of against ATCC 29213. Also, exhibited a notable degree of antibacterial activity against ATCC 29213. subsp. displayed higher antibacterial activities, followed by ssp. and lastly ssp. against ATCC 29213. Lc 26 among all strains of showed a high potential antibacterial activity reaching 40 ± 3 mm against ATCC 29213. All strains of showed a slightly moderate antioxidant activity (10.56 ± 1.28%-26.29 ± 0.05 %). The results of the antibiotic resistance test indicate that all strains of were resistant to cefotaxime, sulfamethoxazole-trimethoprim, and streptomycin and were sensitive to Ampicillin, Amoxicillin, Penicillin G, Teicoplanin, Vancomycin, Gentamicin 500, Tetracycline, and Chloramphenicol. These test results indicate that this strain falls within the criteria of not posing any harmful effects on human health. The important antibacterial properties recorded for all strains were derived from the production of antibacterial active metabolites, such as protein, diacetyl, hydrogen peroxide, and lactic acid, together with the fight for nutrients.
CONCLUSION
This study suggests that the strains of could be added as an antibacterial agent against ATCC 29213 and can provide an important nutritional property for their antioxidant potential.
背景
乳酸菌(LAB)被用作发酵乳制品生产中的起始培养物、各种食品的防腐剂以及益生菌。在我国,尽管乳酸菌在食品保鲜中起主要作用并改善发酵食品的质地和口感,但仍开展了一些相关研究,这就是我们试图评估其益生菌效果的原因。本研究的目的是测定[乳酸菌名称]对金黄色葡萄球菌(ATCC 29213)的抗菌活性,研究其抗氧化活性,并表征它们对18种抗生素的敏感性。
方法
从生鲜牛奶中分离出总共23株乳酸菌(嗜酸乳杆菌亚种、德氏乳杆菌亚种、植物乳杆菌亚种)。使用两种技术进行抗菌活性检测,即营养竞争技术和利用成分性质的技术,采用纸片扩散法。使用市售抗生素纸片在曼-罗戈萨-夏普(MRS)琼脂上测试所研究乳酸菌对不同抗生素的敏感性。检测所有乳酸菌菌株的抗氧化活性。通过2,2-二苯基-1-苦基肼(DPPH)测试[乳酸菌名称]的抗氧化活性。
结果
结果表明,MRS培养基比穆勒-欣顿琼脂(MHA)更适合研究[乳酸菌名称]对金黄色葡萄球菌ATCC 29213的抗菌活性。此外,[乳酸菌名称]对金黄色葡萄球菌ATCC 29213表现出显著的抗菌活性。嗜酸乳杆菌亚种表现出较高的抗菌活性,其次是德氏乳杆菌亚种,最后是植物乳杆菌亚种对金黄色葡萄球菌ATCC 29213的抗菌活性。在所有[乳酸菌名称]菌株中,Lc 26对金黄色葡萄球菌ATCC 29213表现出高潜在抗菌活性,抑菌圈直径达到40±3毫米。所有[乳酸菌名称]菌株均表现出略为中等的抗氧化活性(10.56±1.28%-26.29±0.05%)。抗生素耐药性测试结果表明,所有[乳酸菌名称]菌株对头孢噻肟、磺胺甲恶唑-甲氧苄啶和链霉素耐药,对氨苄西林、阿莫西林、青霉素G、替考拉宁、万古霉素、庆大霉素500、四环素和氯霉素敏感。这些测试结果表明该菌株符合对人类健康不造成任何有害影响的标准。所有[乳酸菌名称]菌株所记录的重要抗菌特性源自抗菌活性代谢产物的产生,如蛋白质、双乙酰、过氧化氢和乳酸,以及对营养物质的竞争。
结论
本研究表明,[乳酸菌名称]菌株可作为针对金黄色葡萄球菌ATCC 29213的抗菌剂添加,并且因其抗氧化潜力可提供重要的营养特性。